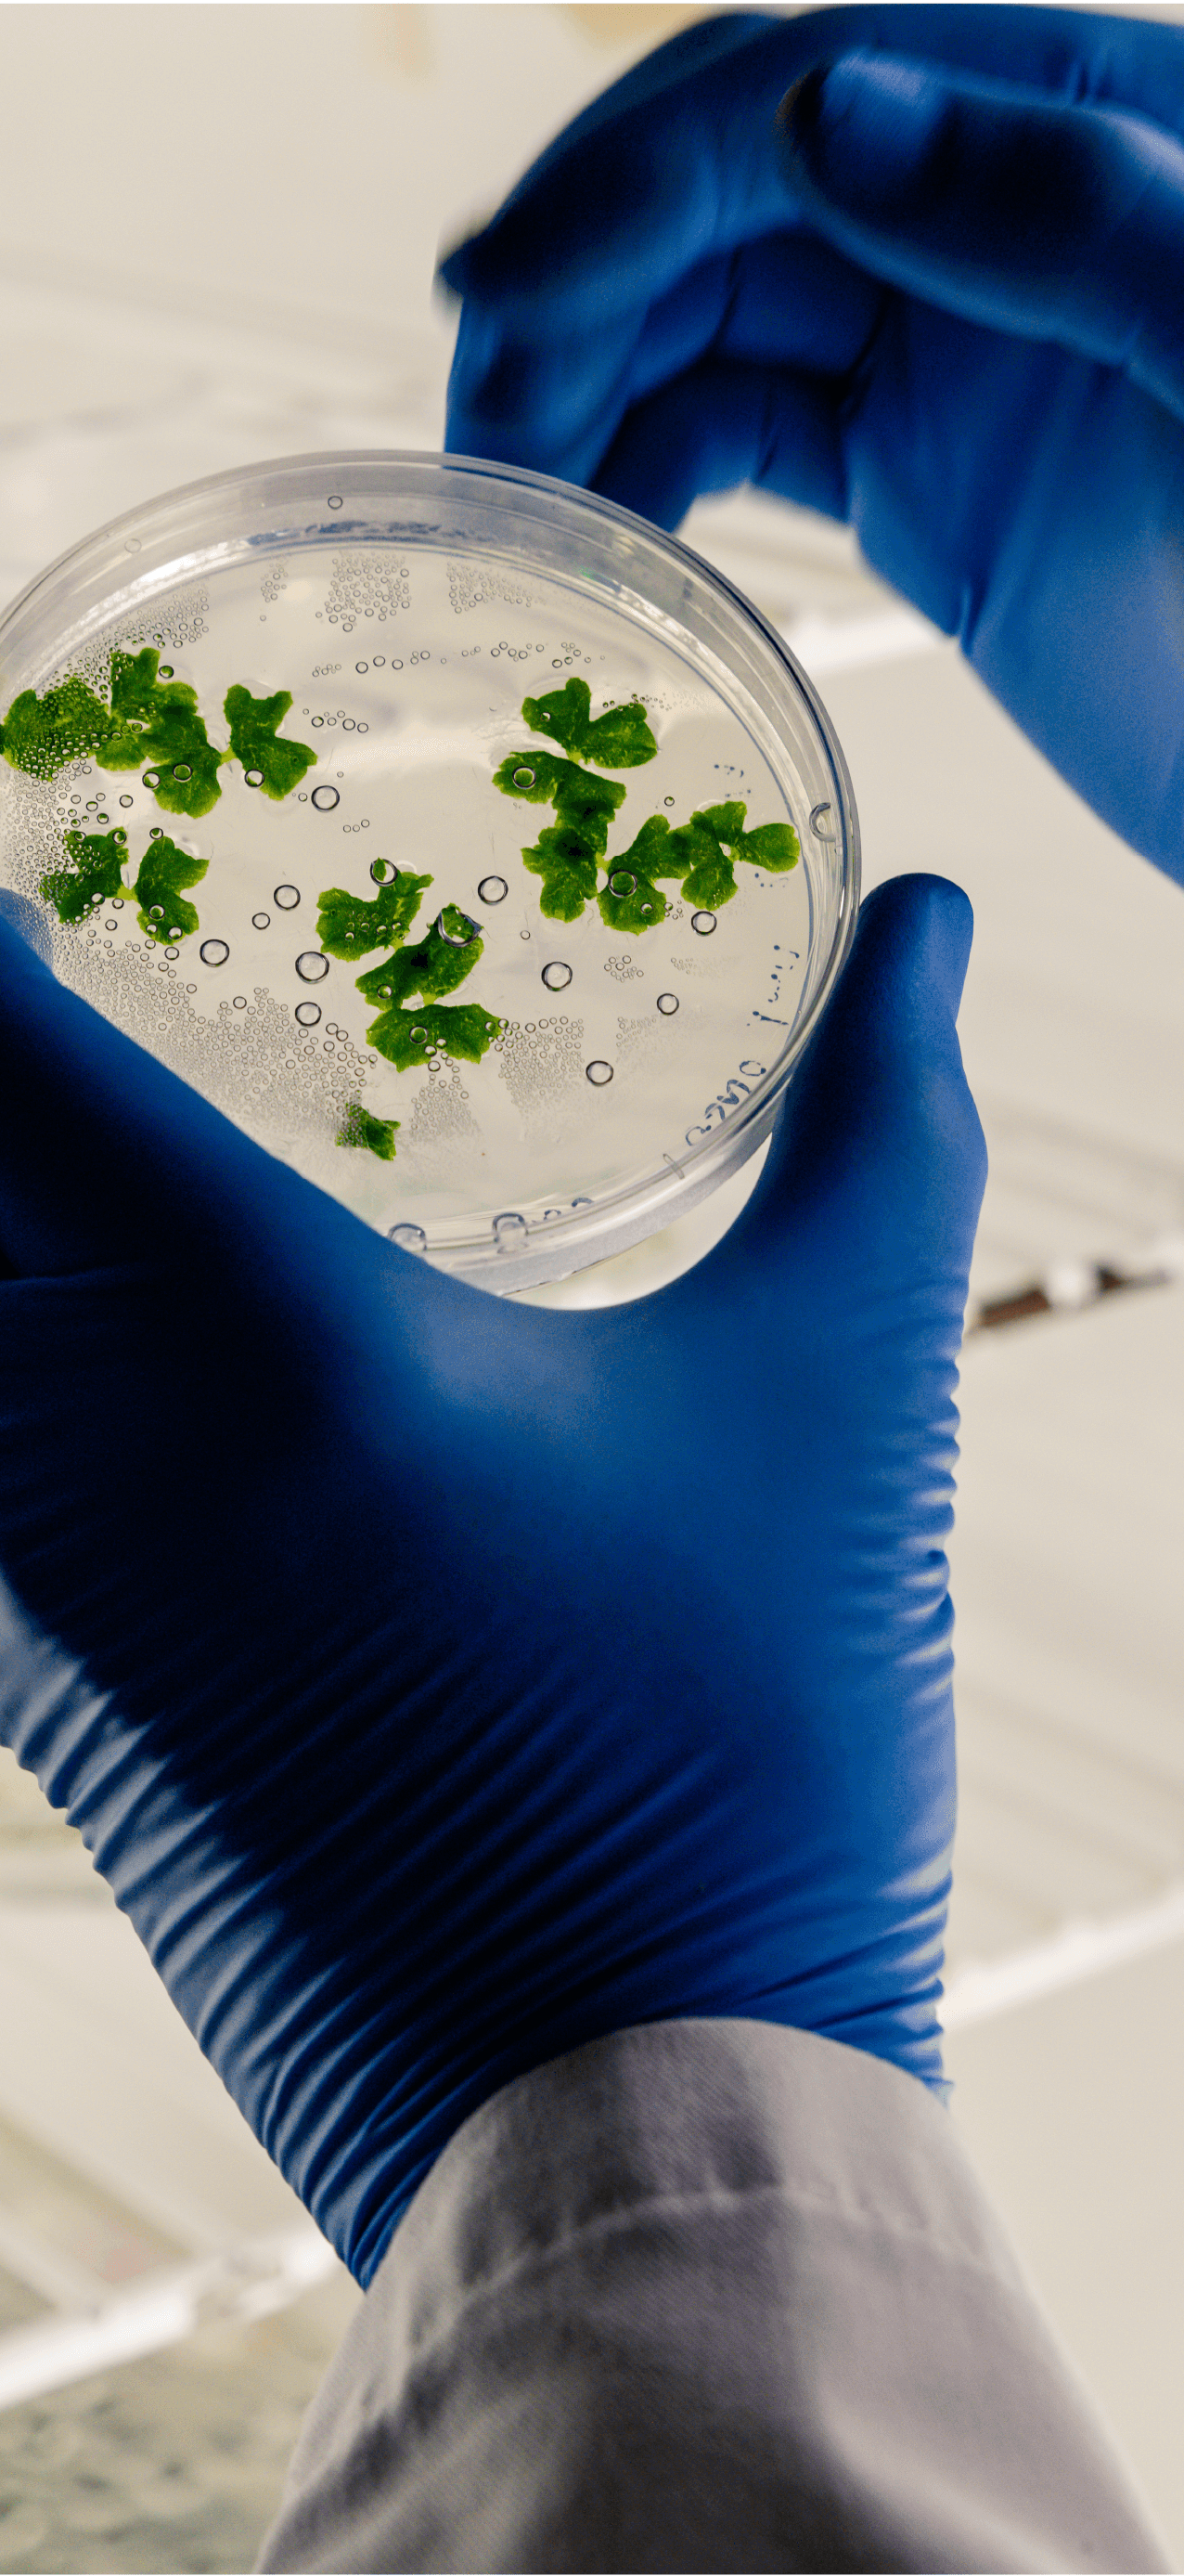

Tasco International Co., Ltd. is one of the leading exporters of protein products and protein nutrition values including fish oil, which is a good ingredient in both human consumption and animal feed.
The Company’s head office is located in Bang Bua Thong, Nonthaburi Province and its factories are located in Samutsakhon Province, renowned for the capital of seafood industry where most feed mill manufacturers located and Chumphon, known as the land that lives between the Gulf of Thailand and the Indian Ocean.
By these geographical advantages and prime manufacturing locations, the Company stands in a strong position in supply management from both sides of the ocean, where fishing activity can be performed alternately the whole year to collect fresh and quality raw materials as well as transportation.





Good For
Consumers
Good For
Employees
Good For
Investors &
Shareholders
Good For
Environment
Good For
Partners
& Society

CORPORATE
GOVERNANCE POLICY

The company commits to good governance principles, aiming for sustainable business growth and returns for investors and shareholders. It operates with honesty, transparency, and efficiency, complying with laws and regulations, respecting shareholder rights, and building positive relationships with government/regulatory agencies.
The company focuses on personnel development, adhering to ethical standards, equality, and fair compensation. It prioritizes a safe and healthy work environment, invests in skill development, and encourages open communication through training sessions and feedback mechanisms.
The company prioritizes customer satisfaction by providing value, quality products, and services, ensuring transparency, fair treatment, and swift issue resolution while maintaining customer confidentiality and ethical business practices.
The company upholds strict environmental standards, promoting resource utilization and safety. It encourages environmental responsibility among personnel, minimizing negative impacts, and actively engages in activities to preserve the environment, support local cultures, and develop society.
The company adheres to good governance, fair partner selection, and ethical competition. It monitors and evaluates suppliers for sustainable development, complies with creditor agreements, and ensures transparent financial reporting. The company promotes free and fair competition without resorting to dishonest or damaging practices against competitors.
CORPORATE SOCIAL RESPONSIBILITY
& SUSTAINABILITY
FAIRNESS
IN BUSINESS
ANTI-
CORRUPTION
RESPECT
FOR HUMAN
RIGHT
FAIR
TREATMENT
IN THE
WORKPLACE
CUSTOMER
RESPONSIBILITY
RESPONSIBILITY
TO TRADE
PARTNERS,
CREDITORS, AND
COMPETITORS
COMMUNITY
OR SOCIAL
PARTICIPATION
CARING
FOR THE
ENVIRONMENT
INNOVATION &
DISSEMINATION
OF INNOVATION
FROM SOCIAL
RESPONSIBILITY
ENVIRONMENT,
& STAKEHOLDERS
AWARDS & CERTIFICATES




